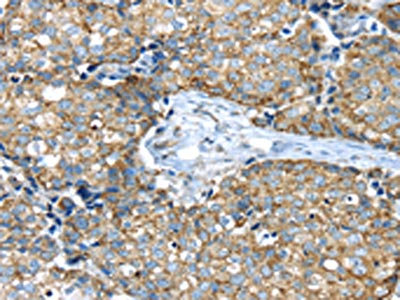

IFNA2 Antibody
-
中文名稱:IFNA2兔多克隆抗體
-
貨號(hào):CSB-PA250552
-
規(guī)格:¥1100
-
圖片:
-
The image on the left is immunohistochemistry of paraffin-embedded Human gastic cancer tissue using CSB-PA250552(IFNA2 Antibody) at dilution 1/40, on the right is treated with synthetic peptide. (Original magnification: ×200)
-
The image on the left is immunohistochemistry of paraffin-embedded Human colon cancer tissue using CSB-PA250552(IFNA2 Antibody) at dilution 1/40, on the right is treated with synthetic peptide. (Original magnification: ×200)
-
-
其他:
產(chǎn)品詳情
-
Uniprot No.:
-
基因名:
-
別名:Alpha 2a interferon antibody; IFN alpha 2b antibody; IFN-alpha-2 antibody; IFNA antibody; Ifna2 antibody; IFNA2_HUMAN antibody; INFA2 antibody; Interferon alpha 2 antibody; Interferon alpha A antibody; Interferon alpha-2 antibody; Interferon alpha-A antibody; LeIF A antibody; LeIFA antibody
-
宿主:Rabbit
-
反應(yīng)種屬:Human
-
免疫原:Synthetic peptide of Human IFNA2
-
免疫原種屬:Homo sapiens (Human)
-
標(biāo)記方式:Non-conjugated
-
抗體亞型:IgG
-
純化方式:Antigen affinity purification
-
濃度:It differs from different batches. Please contact us to confirm it.
-
保存緩沖液:-20°C, pH7.4 PBS, 0.05% NaN3, 40% Glycerol
-
產(chǎn)品提供形式:Liquid
-
應(yīng)用范圍:ELISA,IHC
-
推薦稀釋比:
Application Recommended Dilution ELISA 1:2000-1:5000 IHC 1:50-1:200 -
Protocols:
-
儲(chǔ)存條件:Upon receipt, store at -20°C or -80°C. Avoid repeated freeze.
-
貨期:Basically, we can dispatch the products out in 1-3 working days after receiving your orders. Delivery time maybe differs from different purchasing way or location, please kindly consult your local distributors for specific delivery time.
-
用途:For Research Use Only. Not for use in diagnostic or therapeutic procedures.
相關(guān)產(chǎn)品
靶點(diǎn)詳情
-
功能:Produced by macrophages, IFN-alpha have antiviral activities.
-
基因功能參考文獻(xiàn):
- Genetic mutation IFNA2p.Ala120Thr reduces the binding ability of interferon alpha 2 to the interferon receptor. The weakened binding reduces phosphorylation of transcription factor STAT91, and induces lower expression of interferon-stimulated genes against hepatitis B virus. PMID: 28958921
- Increased protein aggregation and decreased function of IFNA2a upon oxidation correlated with the site of modification identified by proteolysis-coupled mass spectrometry and local structural changes in the protein detected by 2D NMR. PMID: 30324266
- These experimental data establish the retromer complex as a key spatiotemporal regulator of IFNAR endosomal sorting and a new factor in type-I IFN-induced JAK/STAT signalling and gene transcription. PMID: 27917878
- PVT1 interacts with STAT1 to inhibit IFN-alpha signaling and tumor cells proliferation. PMID: 29715456
- Here, we investigated the molecular signals induced by ARI(azacytidine (A) and romidepsin (R), with IFNalpha2 ) treatment and found that this drug combination increased the accessibility to regulatory sequences of IFN-stimulated genes and IFN transcription regulatory factors that were epigenetically silenced in both colorectal cancer cells and Dendritic Cells. PMID: 28615266
- All the tested TLRAs induced greater infant IFN-alpha2 production compared to newborn and adult blood. In contrast, CpG induced greater IFN-gamma, IL-1beta, IL-4, IL-12p40, IL-10 and CXCL8 in newborn than in infant and adult blood. PMID: 27081760
- Interferon-alpha-induced CD100 expression on naive CD8(+) T cells enhances antiviral responses to hepatitis C infection through CD72 signal transduction. PMID: 28222623
- Tumor-associated M2 macrophages in mycosis fungoides acquire immunomodulatory function on exposure to IFN-alpha2a and IFN-gamma. PMID: 27342040
- The variant models of the hIFNalpha-2b displayed structural and conformational changes that signified that changes to hIFNalpha-2b may be a risk factor in addition to other known factors associated with onset/progression of female breast carcinoma. PMID: 27403569
- Increase in serum IFNA2 is associated with adenoma. PMID: 25793917
- Data suggest IFNA2 binding to extracellular domain of IFN receptors IFNAR1 or IFNAR2 promotes proximity between intracellular domains; signaling depends on duration of activation and affinity of binding rather than specific conformational changes. PMID: 26679999
- Report biased expression of human interferon alpha-2b and Escherichia coli methionine amino peptidase genes under control of single promoter in E. coli. PMID: 27087087
- interferon alpha-2b gene mutations were identified among brain tumor patients; highest percentage of frameshift mutations was identified; patients were found to be under environmental stress from contaminated drinking water and from local gamma radiations PMID: 25837663
- PPARalpha activation by an agonist WY-14643 could potentiate IFN-alpha responses, reverse IFN-alpha refractoriness, and enhance viral eradication in hepatocytes. PMID: 25734487
- modulates transitional B cell signaling and function in Systemic Lupus Erythematosus patients PMID: 25678471
- The chronic use of low dose of radiations by occupational workers has a significant correlation with mutational effects on interferon alpha 2b gene, further evident by depressed interferon alpha levels in serum. PMID: 25768396
- IFN-beta was significantly more effective than IFNA2 in protecting human head and neck squamous cell carcinoma lines from oncolysis by vesicular stomatitis. PMID: 25995245
- The structure, mechanism of action and biological activities of IFNalpha2. [Review] PMID: 25982860
- Therefore, this study associated, for the first time, in a large panel of pancreatic cancer cell lines the effects of IFN-alpha/-beta with the expression of type-I IFN receptors. PMID: 24460759
- IFN-1ant may be a therapeutic candidate for the treatment of specific viral infections without inducing the immunomodulatory and antiproliferative functions of wild-type IFN. PMID: 24866020
- IFNalpha serum marker could be used to identify a group of rheumatoid Arthritis patients with increased disease activity, endothelial progenitor cell imbalance, enhanced proinflammatory profile and higher cardiovascular risk. PMID: 24465874
- these findings establish critical and essential roles for SKAR in the regulation of mRNA translation of IFN-sensitive genes and induction of IFN-alpha biological responses. PMID: 25049393
- Hepatitis B virus could induce both SOCS-1 and 3 expression regardless of endogenous interferon level. PMID: 24636575
- IL6 is an inducer of IRF9 expression in prostate cancer and a sensitizer for the antiproliferative effects of IFNalpha2. PMID: 23913484
- IFNA2 inhibits viral protein expression through PKR activation, leading to a decrease of viral protein synthesis. PMID: 24089560
- These studies identify IFNalpha derived from lymph nodes, rather than blood leukocytes, as a possible source of the IFN-I signature that contributes to immune activation in HIV-1 infection PMID: 23437155
- Pre-treatment waking hypothalamic-pituitary-adrenal (HPA) axis response is greater in subjects switching to major depressive disorder during INFalpha2a treatment and may constitute a vulnerability factor in patients with hepatitis C virus infection. PMID: 22571879
- The association with clinical disease and activation of multiple inflammatory cytokines supports a role for IFN-alpha2 in disease perpetuation in a large subset of systemic lupus erythematosis patients. PMID: 23213068
- Obese subjects showed a decreased ability to produce IFN-alpha and IFN-beta in response to TLR ligands; this response was associated with increased basal levels of SOCS3 but not SOCS1. PMID: 22951153
- analysis of how an N-acetylgalactosamine residue at threonine 106 modifies the dynamics and structure of interferon alpha2a around the glycosylation site PMID: 23184955
- The authors concluded that IFN-alpha-induced inhibition of miR-122 may negatively affect the anti-hepatitis B virus function of IFN-alpha. PMID: 23055569
- Results showed that missense mutations in transmembrane protein 2 p.Ser1254Asn, interferon alpha 2 p.Ala120Thr, its regulator NLR family member X1 p.Arg707Cys, and complement component 2 p.Glu318Asp were associated with chronic hepatitis B. PMID: 22610944
- Successful immunostimulation by IFNalpha2b may help tongue squamous cell carcinoma patients in clinical improvement. PMID: 22885264
- Data indicate that the combination of AAV2.IL-4 and AAV2.IFN-alpha was not significantly different as compared to AAV2.IL-4 alone. PMID: 22685550
- The crystal structures of two human type I IFN ternary signaling complexes containing IFNalpha2 and IFNomega reveal recognition modes and heterotrimeric architectures that are unique among the cytokine receptor superfamily but conserved between type I IFNs. PMID: 21854986
- Structural AA changes in the C-helix interacting with IFNAlphaR1 may change the signaling dynamics leading to elevated APOBEC3 & lower IDO by an engineered mutant derived from the amino-terminal region of IFNalpha21b and the COOH-terminus from IFNalpha2c. PMID: 21757613
- interferon-stimulated genes which exerts its negative feedback action by taking advantage of the weakness of IFNalpha2 binding to the receptor PMID: 22731491
- protein kinase, DNA-activated catalytic polypeptide (PRKDC), was confirmed to play a role in MyD88-induced IFNA2 activation and IL-8 secretion PMID: 22332739
- variation at IFNA2 -173 and IFNA8 -884 conditions reduced IFN-alpha production, and increased susceptibility to SMA and mortality PMID: 22570109
- Data indicate that the production of IFN-alpha in supernatant of transfected cells was about 3.15 ng/mL. PMID: 22482409
- IFNalpha rapidly down-regulates BCL-6 mRNA in purified mouse normal germinal center B cells. PMID: 22204827
- we have demonstrated that IFNalpha2, a type I interferon, increases the expression of TLR3 on human dermal fibroblasts PMID: 21223583
- Interferon alpha 2 regulates MAPK and STAT1 pathways in human hepatoma cells. PMID: 21466707
- Degos disease is a distinct vascular injury syndrome whereby a dysregulated interferon-alpha response in concert with membranolytic attack complex deposition may contribute to the unique vascular changes. PMID: 21411783
- These findings indicate that the expression of MxA, 2',5'-OAS and PKR are up-regulate by PI3K-AKT signal pathway, and Raf-MEK-ERK signal pathway has a negative regulatory effect on the expression of MxA and no significant effect on 2',5'-OAS and PKR. PMID: 20309637
- Studies indicate that it remains unclear whether interruption of IFNalphaA and IL-10 signaling in the absence of CD73 activity results from a deficiency of its product adenosine or an accumulation of its substrate nucleotides. PMID: 21057730
- Data show that pDCs and type I IFNs promote inflammatory responses and wound healing in injured skin. PMID: 21115688
- The result suggests that hyper-induction of TNF-alpha in human macrophages is not always associated with a highly pathogenic phenotype of avian and human influenza viruses. PMID: 20532927
- Strategies are described to maximize expression of rightly processed human INF alpha2b protein in Pichia. PMID: 20159042
- Data show that serum concentrations of pegylated interferon alpha-2b increased in a dose-related manner. PMID: 19621225
顯示更多
收起更多
-
亞細(xì)胞定位:Secreted.
-
蛋白家族:Alpha/beta interferon family
-
數(shù)據(jù)庫(kù)鏈接:
Most popular with customers
-
-
YWHAB Recombinant Monoclonal Antibody
Applications: ELISA, WB, IHC, IF, FC
Species Reactivity: Human, Mouse, Rat
-
Phospho-YAP1 (S127) Recombinant Monoclonal Antibody
Applications: ELISA, WB, IHC
Species Reactivity: Human
-
-
-
-
-